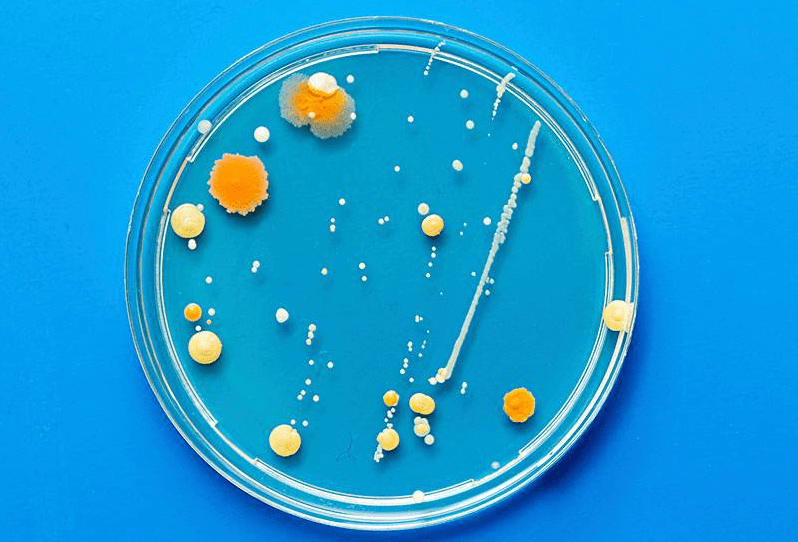

土著菌就生活在我们周围的自然环境中,是多种有益微生物的混合群,土著微生物按好嫌气性分有好气菌、嫌气菌;按菌种分有酵母菌、曲霉菌、放线菌、乳酸菌、芽孢菌等。土著菌是自然界中不可缺少的一部分。树叶枯落在地上,经土著微生物发酵分解之后变成营养丰富的食品被成千上万的小昆虫、蚯蚓、小动物采食,然后排出粪便再供植物生长。
1、基本简介
有益微生物是自然界中物质循环生态链不可缺少的环节。自然环境中的动物尸体和粪便、植物残骸和叶子,经有益微生物发酵分解之后变成营养丰富的食品被成千上万的小昆虫、蚯蚓、小动物采食,再被高等动物利用,然后排出粪便再供植物生长。所有这些物质和营养的流通环节都离不开有益微生物。而随着养殖密度的加大,抗生素的过度使用,使得目前自然条件下的有益微生物数量不能满足现有水平。本方法就是模拟自然条件下的养殖环境,通过对自然条件下有益微生物进行采集、分离提纯、复壮扩培后,再行添加进养殖过程中以达到对养殖过程中的废弃物进行分解处理。而这些有益微生物就生活在我们周围的自然环境中,走进阔叶树林或竹林,在落叶且腐殖质多地方,扒开树叶或杂草就可以看到细丝壮白色菌落,这就是微生物。只不过这些微生物是有益微生物和有害微生物的混合体,需要进行分离。有益微生物按好嫌气性分有好气菌、嫌气菌;按菌种分有酵母菌、曲霉菌、放线菌、乳酸菌、芽孢菌等。把做的稍微有一点硬的大米饭(1kg~1.5kg),装入用干净杉木板做的小木箱(25cm×20cm×10cm)约三分之一,大米饭上面盖上宣纸,封好口,将其埋在当地山上落叶聚集较多的山谷树林中。为防止野生动物糟蹋,木箱最好罩上铁丝网。夏季经三~五天,春秋经六~七天,周边的土著微生物潜入到米饭中,在米饭上形成白色菌落(放置时间稍长时会形成各种颜色菌落,虽然也能利用,但最好还是用白色菌落)。一般情况下,采来的样品可以直接进行分离,但是如果样品中我们所需要的菌类含量并不很多,而另一些微生物却大量存在。此时,为了容易分离到所需要的菌种,让无关的微生物至少是在数量上不要增加,即设法增加所要菌种的数量,以增加分离的几率。可以通过选择性的配制培养基(如营养成分、添加抑制剂等),选择一定的培养条件(如培养温度、培养基酸碱度等)来控制。具体方法是根据微生物利用碳源的特点,可选定糖、淀粉、纤维素,或者石油等,以其中的一种为唯一碳源,那么只有利用这一碳源的微生物才能大量正常生长,而其他微生物就可能死亡或淘汰。对G一菌有选择的培养基(如结晶紫营养培养基、红—紫胆汁琼脂、煌绿胆汁琼脂等)通常含有5%~10%的天然提取物。在分离细菌时,培养基中添加浓度一般为50μg/m1的抗真菌剂(如放线菌酮和制霉素),可以抑制真菌的生长。在分离放线菌时,通常于培养基中加入1~5m1天然浸出汁(植物、岩石、有机混合腐质等的浸出汁) 作为最初分离的促进因子,由此可以分离出更多不同类型的放线菌类型;放线菌还可以十分有效地利用低浓度的底物和复杂底物(如几丁质),因此,大多数放线菌的分离培养是在贫脊或复杂底物的琼脂平板上进行的,而不是在含丰富营养的生长培养基上分离的;在放线菌分离琼脂中通常加入抗真菌剂制霉菌素或放线菌酮,以抑制真菌的繁殖;此外,为了对某些特殊种类的放线菌进行富集和分离,可选择性地添加一些抗生素(如新生霉素)。在分离真菌时,利用低碳/氮比的培养基可使真菌生长菌落分散,利于计数、分离和签定;在分离培养基中加入一定的抗生素如氯霉素、四环素、卡那霉素、青霉素、链霉素等即可有效地抑制细菌生长及其菌落形成;抑制细菌的另外一些方法有:在使用平皿之前,将平皿先干燥3~4天;降低培养基的pH值或在无法降低pH时,加入1:30000玫瑰红。这样有利于下阶段的纯种分离。 通过增殖培养,样品中的微生物还是处于混杂生长状态。因此还必须分离,纯化。在这一步,增殖培养的选择性控制条件还应进一步应用,而且要控制得细一点,好一点。同时必须进行纯种分离,常用的分离方法有稀释分离法、划线分离法和组织分离法。稀释分离法的基本方法是将样品进行适当稀释,然后将稀释液涂布于培养基平板上进行培养,待长出独立土著菌的单个菌落,进行挑选分离。划线分离法要首先倒培养基平板,然后用接种针(接种环)挑取样品,在平板上划线。划线方法可用分步划线法或一次划线法,无论用哪种方法,基本原则
通过增殖培养,样品中的微生物还是处于混杂生长状态。因此还必须分离,纯化。在这一步,增殖培养的选择性控制条件还应进一步应用,而且要控制得细一点,好一点。同时必须进行纯种分离,常用的分离方法有稀释分离法、划线分离法和组织分离法。稀释分离法的基本方法是将样品进行适当稀释,然后将稀释液涂布于培养基平板上进行培养,待长出独立土著菌的单个菌落,进行挑选分离。划线分离法要首先倒培养基平板,然后用接种针(接种环)挑取样品,在平板上划线。划线方法可用分步划线法或一次划线法,无论用哪种方法,基本原则 是确保培养出单个菌落。组织分离法主要用于食用菌菌种或某些植物病原菌的分离。分离时,首先用10%漂白粉或0.1%升汞液对植物或器官组织进行表面消毒,用无菌水洗涤数次后,移植到培养皿中的培养基上,于适宜温度培养数天后,可见微生物向组织块周围扩展生长。经菌落特征和细胞特征观察确认后,即可由菌落边缘挑取部分菌种进行移接斜面培养。对于有些微生物如毛霉、根霉等在分离时,由于其菌丝的蔓延性,极易生长成片,很难挑取单菌落。常在培养基中添加0.1%的去氧胆酸钠或在察氏培养基中添加0.1%的山梨糖及0.01%的蔗糖,利于单菌落的分离。经过分离培养,在平板上出现很多单个菌落,通过菌落形态观察,选出所需菌落,然后取菌落的一半进行菌种鉴定,对于符合目的菌特性的菌落,可将之转移到试管斜面纯培养。这种从自然界中分离得到的纯种称为野生型菌株,它只是筛选的第一步,所得菌种是否具有生产上的实用价值,能否作为生产菌株,还必须采用与生产相近的培养基和培养条件,通过三角瓶的容量进行小型发酵试验,以求得适合于工业生产用菌种。这一步是采用与生产相近的培养基和培养条件,通过三角瓶的容量进行小型发酵试验,以求得适合于工业生产用菌种。如果此野生型菌株产量偏低,达不到工业生产的要求,可以留之作为菌种选育的出发菌株。
是确保培养出单个菌落。组织分离法主要用于食用菌菌种或某些植物病原菌的分离。分离时,首先用10%漂白粉或0.1%升汞液对植物或器官组织进行表面消毒,用无菌水洗涤数次后,移植到培养皿中的培养基上,于适宜温度培养数天后,可见微生物向组织块周围扩展生长。经菌落特征和细胞特征观察确认后,即可由菌落边缘挑取部分菌种进行移接斜面培养。对于有些微生物如毛霉、根霉等在分离时,由于其菌丝的蔓延性,极易生长成片,很难挑取单菌落。常在培养基中添加0.1%的去氧胆酸钠或在察氏培养基中添加0.1%的山梨糖及0.01%的蔗糖,利于单菌落的分离。经过分离培养,在平板上出现很多单个菌落,通过菌落形态观察,选出所需菌落,然后取菌落的一半进行菌种鉴定,对于符合目的菌特性的菌落,可将之转移到试管斜面纯培养。这种从自然界中分离得到的纯种称为野生型菌株,它只是筛选的第一步,所得菌种是否具有生产上的实用价值,能否作为生产菌株,还必须采用与生产相近的培养基和培养条件,通过三角瓶的容量进行小型发酵试验,以求得适合于工业生产用菌种。这一步是采用与生产相近的培养基和培养条件,通过三角瓶的容量进行小型发酵试验,以求得适合于工业生产用菌种。如果此野生型菌株产量偏低,达不到工业生产的要求,可以留之作为菌种选育的出发菌株。 活性好的土著菌可以用由人工培养、扩陪成纯度高的微生物菌群!
土著菌发酵床养猪技术、养鸡技术是利用自然环境中的生物资源,采集土壤中的多种有益微生物进行培养扩繁,使其形成有相当活力的微生物母种,再按一定比例将微生物母种与锯木屑等辅料和活性剂混合发酵形成有机垫料。让猪、鸡从小到大都生活在这种有机垫料上,猪、鸡的排泄物被有机垫料里的微生物迅速降解、消化,不需进行人工处理,达到零排放。
 是确保培养出单个菌落。组织分离法主要用于食用菌菌种或某些植物病原菌的分离。分离时,首先用10%漂白粉或0.1%升汞液对植物或器官组织进行表面消毒,用无菌水洗涤数次后,移植到培养皿中的培养基上,于适宜温度培养数天后,可见微生物向组织块周围扩展生长。经菌落特征和细胞特征观察确认后,即可由菌落边缘挑取部分菌种进行移接斜面培养。
是确保培养出单个菌落。组织分离法主要用于食用菌菌种或某些植物病原菌的分离。分离时,首先用10%漂白粉或0.1%升汞液对植物或器官组织进行表面消毒,用无菌水洗涤数次后,移植到培养皿中的培养基上,于适宜温度培养数天后,可见微生物向组织块周围扩展生长。经菌落特征和细胞特征观察确认后,即可由菌落边缘挑取部分菌种进行移接斜面培养。